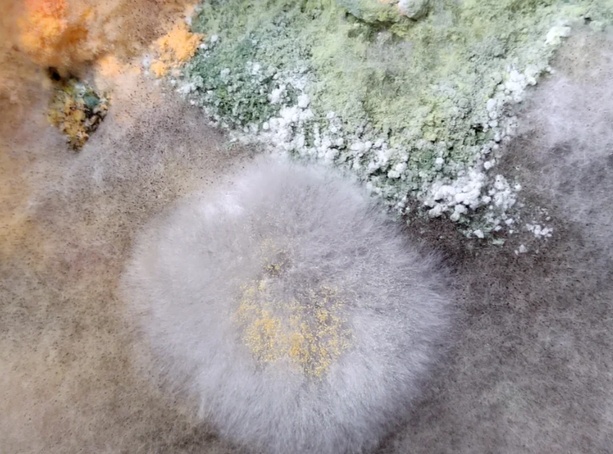

家电是生活的好帮手。
这是很多人的“固有印象”,但如今市面上的家电种类繁多,数不胜数,盲目跟风将会吃灰占地方,还多花冤枉钱。
比如下面这7种“良心坏透”的家电,谁买谁后悔!
大家快自查下,让我看看,谁还上赶着当冤种?
⑴水龙头净水器
我们平时使用的自来水需要在水库进行消毒过滤等种种程序,达到安全的门槛,然后再通过地下管道运输到用户家中。
所以我们得到的自来水品质≠出产品质,换句话来说,自来水虽然经过了国家认证安全,实际上可能在运输的过程中遭到了污染,长期饮用,对身体有害。
为此,不少人就购买净水器,但反渗透和超滤净水器的安装使用成本太高,不是人人都能承担得起,所以有些人就另辟蹊径,选择水龙头净水器。
价格低廉,安装方便,可以过滤水中的泥沙铁锈等,好像听上去还不错,殊不知,巨坑!
1.水龙头净水器的过滤精细度非常低,连铁锈泥沙都无法100%过滤干净。
2.无法自动清洗,如果自来水遭到了重度污染,用上几天,水龙头净水器就会失去效用,还会反过来污染自来水,进一步拉低自来水的品质。
⑵内衣洗衣机
不想手动清洗内衣,但用家里的大洗衣机就担心会造成污染,对身体有害,所以很多人就购买了内衣洗衣机。
容量虽小,但用来洗内衣刚刚好,洗的干净又能杀菌消毒。
但实际上完全没必要,这完全是无良商家埋下的坑,花上千元买内衣洗衣机还不如花几百元买一个小容量的滚筒或波轮洗衣机。
和内衣洗衣机相比,小容量的滚筒或波轮洗衣机电机动力更足,洗的更干净,而且除了可以用来洗内衣,还可以用来洗夏季的衣物,一物多用,更经济实惠。
⑶烘干一体机
这种家电不仅能够把衣服洗干净,同时还能把衣服烘干到上身的地步,在宣传时常常给人一种“1+1>2”的感觉,非常适合小户型,可以从源头上解决占地问题。
但实际上等用过之后就会发现,其实这种多功能的家电特别坑,虽然既能洗衣服又能烘干,但价格是真贵,是普通洗衣机的好几倍。
而且烘干的效率非常低,烘干的效果也不尽如人意,非常容易出现褶皱和残留毛球头发的现象。
最可恨的是这种家电“买得起未必用得起”,不仅费电,而且特别容易出故障,维修一次动辄就要好几百,远不如“洗衣机+热泵式烘干机”更实用。
⑷高温蒸汽拖把
传统的拖把只能打扫干净肉眼可见的灰尘和头发,而蒸汽拖把却可以瞬间喷射出120℃的高温水蒸气,到杀菌消毒的目的。
引得无数人入坑,其实全是无良商家的“套路”。
蒸汽拖把和地面接触的时间太短,根本无法真正的达到杀菌消毒的目的;
用在木地板上,会加速木地板老化变形;
水箱容量特别少,每次拖地可能都要多次添水,比传统的拖把还费时费力。
有些还带着长长的电源线,不留神就会绊倒,亦或者导致漏电引发火灾。
⑸刀具消毒机
为了避免病从口入,很多人在刀具消毒机上市的时候就纷纷下单。殊不知,这种家电嚎头>实用性。
作为“卖点”的杀菌消毒功能,其实本质上就是紫外线,无法从根源上杀死细菌。
而且多数无法拆卸清洁,时间长了,将会藏污纳垢,滋生细菌异味,加重刀具污染问题。
⑹自动炒菜机
听名字很高大上,其实并不是完全自动。
洗菜,摘菜,切菜,盛菜……都需要我们自己动手,它只是帮人省去了“翻炒”的动作而已!
⑺带语音功能的马桶
自从马桶进行智能化升级后,变成了智能家电,给人们的生活带来了许多的便捷。
比如泡泡盾、自动翻盖、妇洗等功能一直好评如潮,但有一些良心坏透的商家,为了吸引眼球,特意的开发了一些花里胡哨、中看不中用的功能。
像语音对话功能、唱歌功能……,听上去那叫一个高大上,但实际上马桶作为卫浴用品,无良商家早已忘记了它的原始功能。
建议大家,选购智能马桶时一定要谨慎购买,擦亮眼睛,选购坚固美观实用性的半智能马桶,一般2000多元就能搞定,舒适度高,技术成熟,一般不会出故障。
写在最后,
科技的进步就像一把双刃剑,有利又有弊,所以大家在购买家电时一定要擦亮眼睛,不因价格便宜盲目跟风,不因价格贵就头脑一热立马下单!